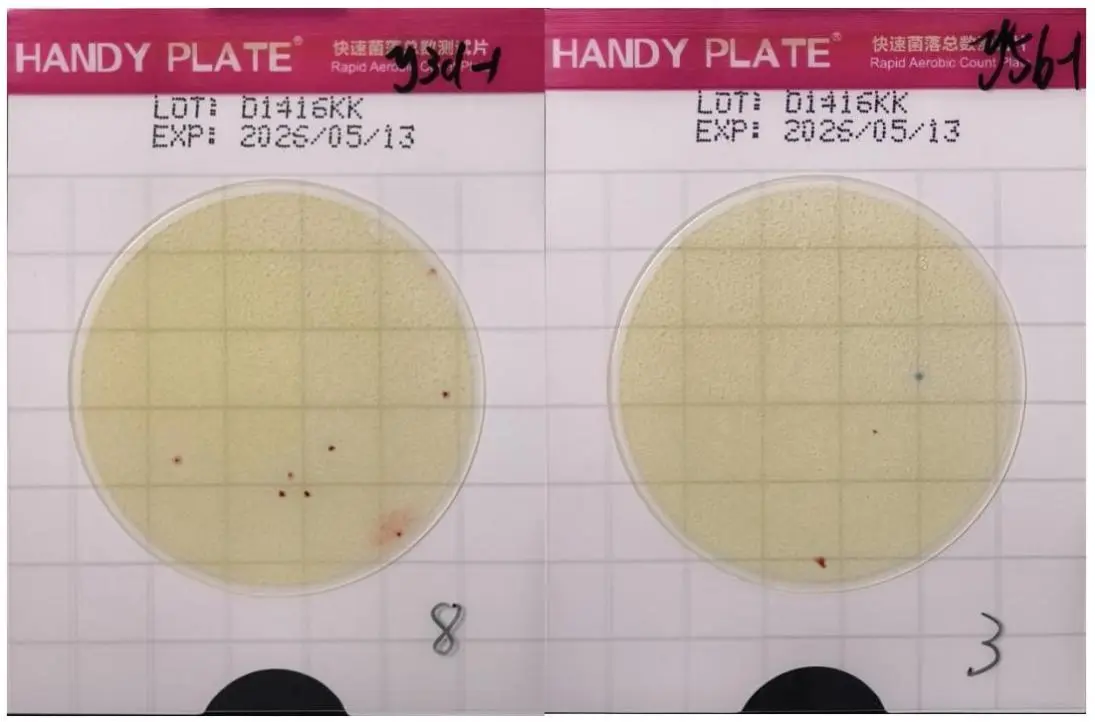
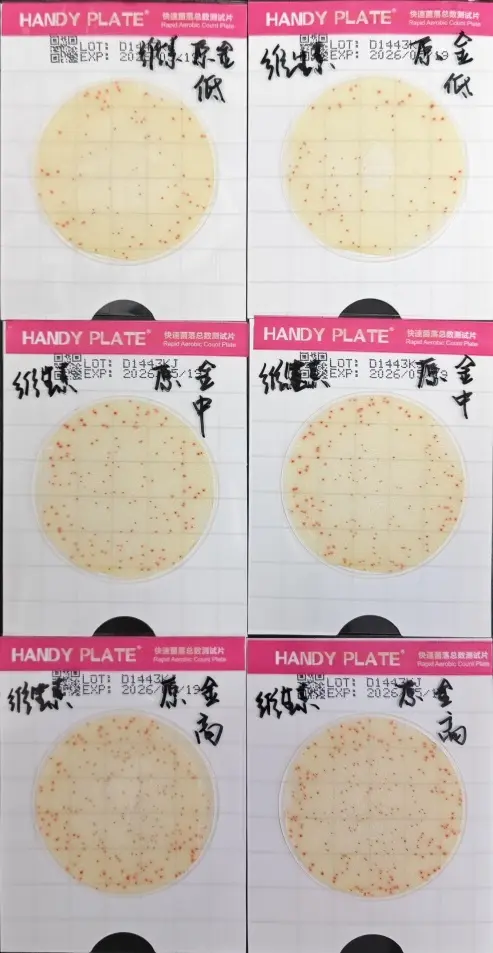
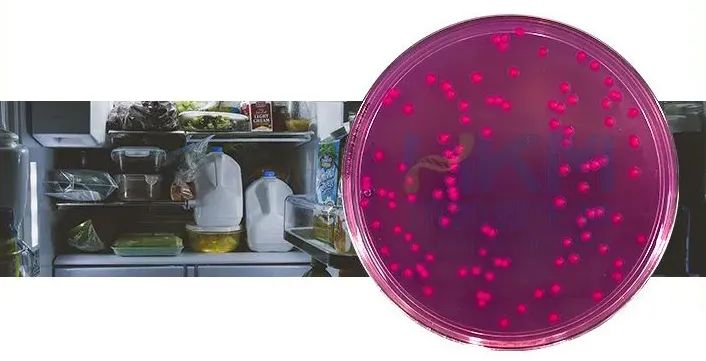

-
环凯HandyPlate®测试片在方便面类食品检测中的应用
针对方便面行业微生物检测存在的操作繁琐、耗时长、成本高三大痛点,环凯推出HandyPlate®快速菌落测试片。该产品采用预置冷水凝胶与复合酶显色技术,开袋即用三步完成检测,在脱水蔬菜、高油酱料等复杂基质中表现优异。经Bland-Altman检验证实,其与国标平板法检测结果一致性达95%以上,检测效率提升5倍,废弃物处理更安全,助力食品检测从实验室走向生产线。
2025-04-07 -

环凯生物酶底物法检测系统(含质控样)-酶底物法检测水中总大肠菌群、粪(耐热)大肠菌群、大肠埃希氏菌解决方案!
环凯生物研发的酶底物法水质检测系统,通过高特异性MMO-MUG培养基和全自动判读技术,实现24小时快速检测饮用水、污水及地表水中的总大肠菌群、粪大肠菌群及大肠埃希氏菌。系统符合GB/T5750-2023和HJ1001-2018国家标准,提供质控样确保准确性,适用于疾控中心、环境监测站及污水处理厂,兼具高效性、灵敏度和操作便捷性。
2023-12-05 -

食品微生物检验GB4789系列解决方案
解读食品微生物检验GB4789系列菌落总数、大肠菌群、唐菖蒲伯克霍尔德氏菌(椰毒假单胞菌酵米面亚种)、沙门氏菌等食源性致病菌检验极其注意事项。
2021-02-23 -
环凯HandyPlate®测试片在饮料行业的应用
环凯生物推出HandyPlate®快速菌落总数测试片,专为饮料检验打造。采用独特滤膜法,允许10ml饮料过滤检测,杜绝假阴性;含缓冲体系,中和饮料酸碱度,解决pH抑制问题。操作简便,无需配制培养基,24小时显色,菌落易观察。经实验验证,对极端pH饮料样品检测可靠,显著提升饮料行业检验效率与准确性。
2025-04-02 -

HandyPlate®快速菌落总数测试片在调味品行业的应用
当你检测调味品时,是否会因传统平板计数琼脂PCA耗时又费力而烦恼?是否担心样品pH对菌落生长会造成影响?现在,环凯生物推出了HandyPlate®快速菌落总数测试片(调味品款),能够解决以上难题!
2025-03-31 -

食品微生物检验GB4789.4-2016 沙门氏菌检验及注意事项
食品微生物检验GB4789.4-2016 沙门氏菌检验及注意事项详解沙门氏菌生物学特性,沙门氏菌的检验、沙门氏菌检验所用培养基原理解析、沙门氏菌恒温荧光核酸快速检测等。
2020-09-21 -

GB4789.6-2016 致泻大肠埃希氏菌检验及注意事项
致泻大肠埃希氏菌:一类能引起人体以腹泻症状为主的大肠埃希氏菌,可经过污染食物引起人类发病。
2021-11-26 -
更新 | GB4789.8-2016 小肠结肠炎耶尔森氏菌检验及其注意事项
GB4789.8-2016 小肠结肠炎耶尔森氏菌检验及其注意事项
2024-05-21 -

【新!】食品微生物检验GB4789.2-2022菌落总数测定及注意事项
菌落总数测定及注意事项详解GB4789.2-2022菌落总数测定变更情况、质量控制和疑难解析、菌落总数测试片法、所需培养基试剂等内容。
2020-08-28 -

更新 | GB 4789.13-2012 食品微生物学检验 产气荚膜梭菌检验
2024-07-03






